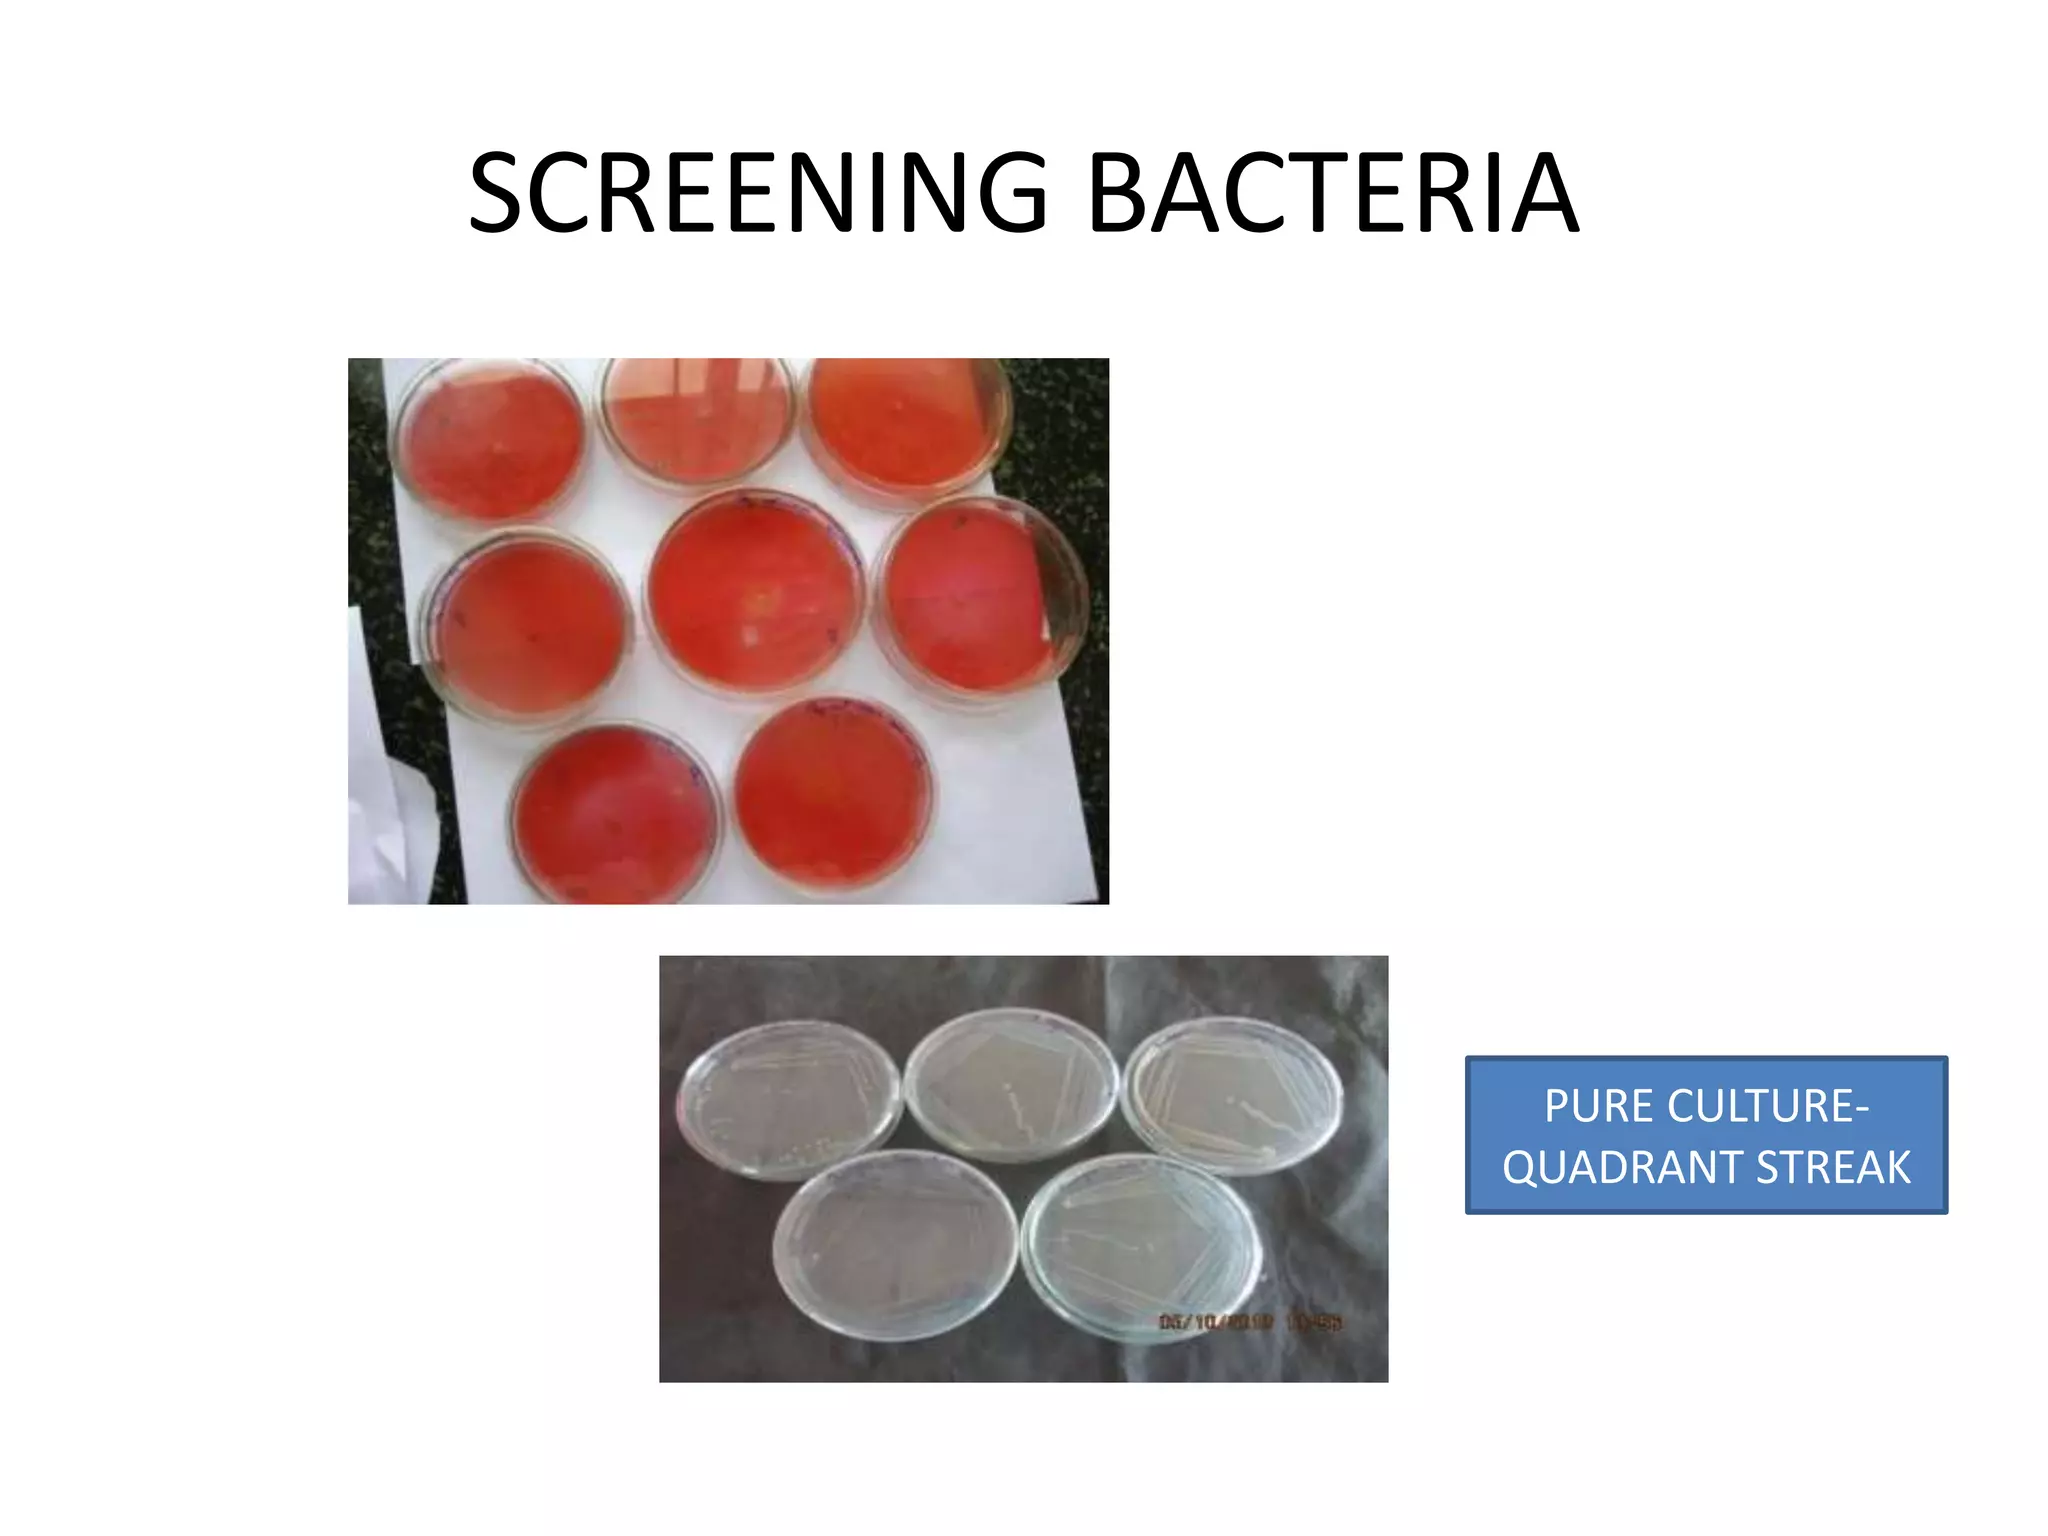
SCREENING BACTERIA
PURE CULTURE-
QUADRANT STREAK

Embed presentation
Downloaded 147 times



























This document discusses various bioprocessing techniques including froth flotation, bubble columns, air-lift reactors, screening of fungi and bacteria, pure culture techniques, downstream processing methods like electrodialysis, crystallization, chemical conversion, and drying. It also mentions parts of fermenters and other processes involved in wine production as well as distilling of alcoholic beverages. The document is authored by Sreeremya.S and appears to be about bioprocess technology.